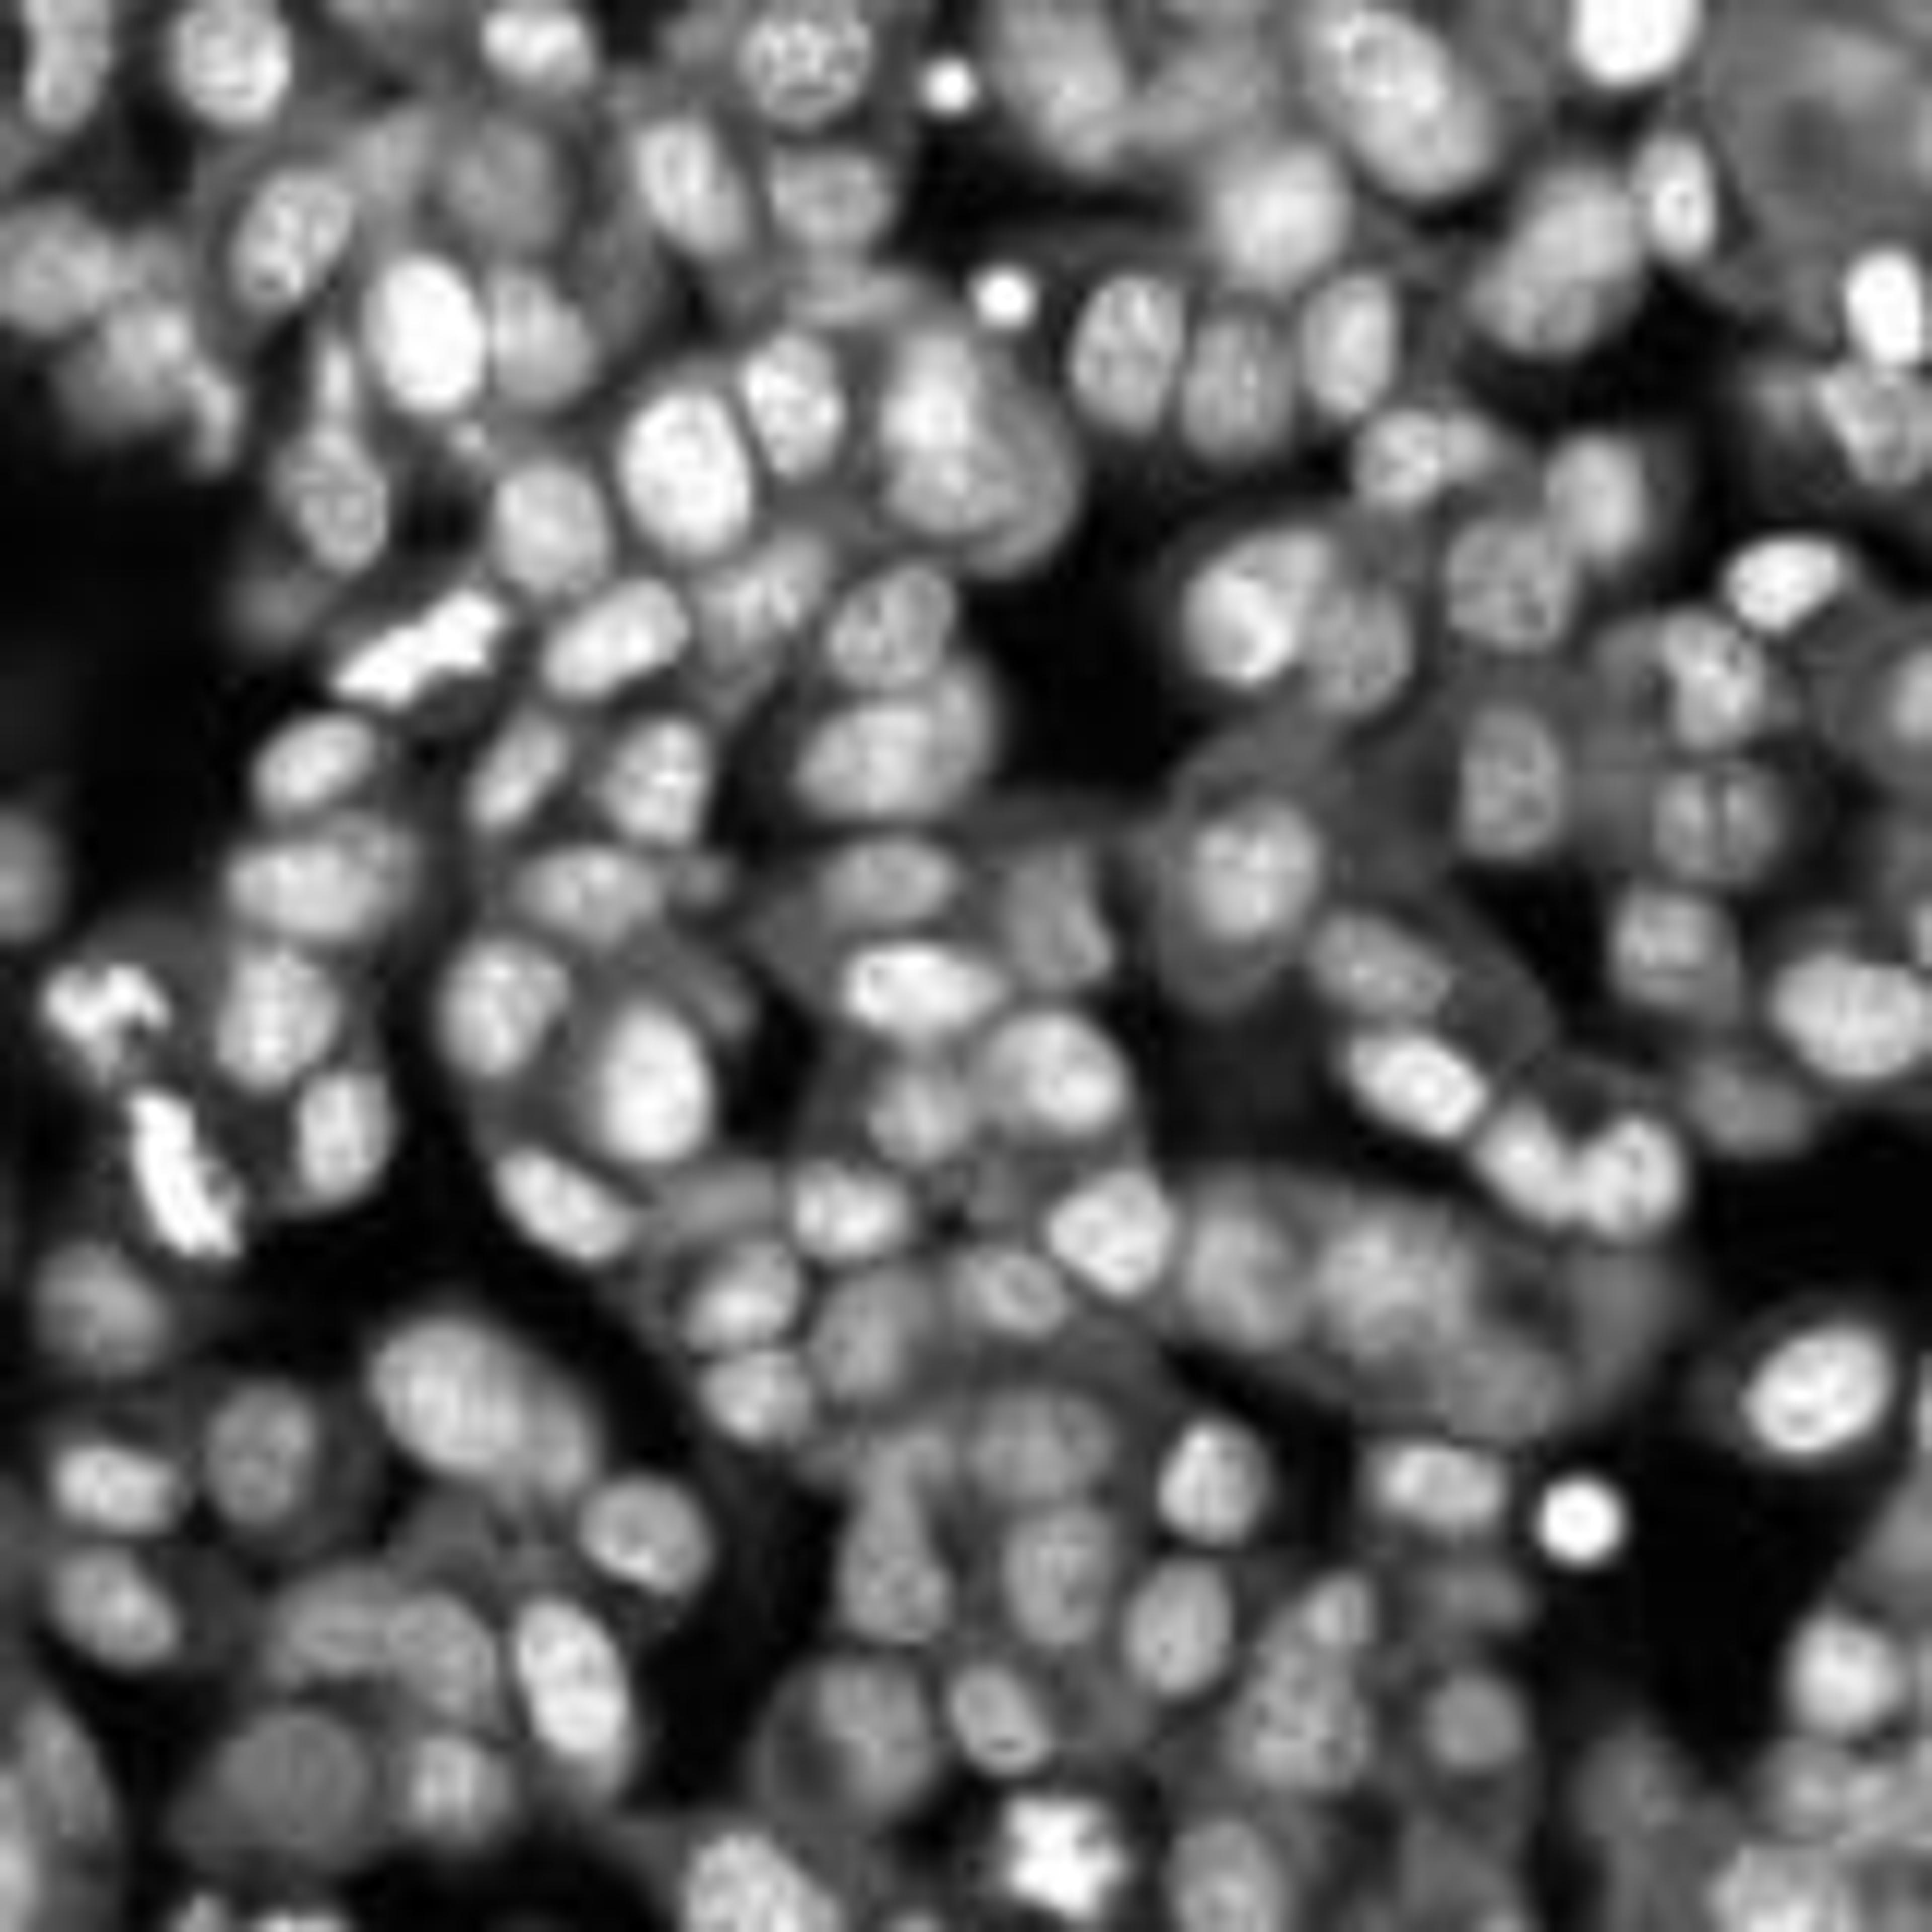

DRAQ5
The proven far-red probe for live or fixed cells, spectrally compatible with UV / Vis-range fluors.

The supplier does not provide quotations for this product through SelectScience. You can search for similar products in our Product Directory.
Easy and useful
Neuroscience, confocal microscopy
It's easy to identify the target, and the signal is strong enough to capture the image.
Review Date: 28 Nov 2024 | Biostatus Limited
Molecular Biology
Confocal microscopy
Easy to use and highly productive
Review Date: 5 Sept 2024 | Biostatus Limited
Works as expected
DNA labeling for nano-imaging
It is easy to use. The photo-stability and brightness are great. The far-red spectrum also provides less potential damages to DNA structures.
Review Date: 26 Aug 2024 | Biostatus Limited
Good
Immunofluorescence
Works as expected
Review Date: 1 Aug 2024 | Biostatus Limited
Very simple use to detect the nuclei and the signal is generally bright.
To visualize nuclei for basic research
It is easy to use and the staining is generally bright. In my case it was helpful since it was not possible to detect the fluorescence released by other compounds used to visualize nuclei such as dapi or hoechst 33342.
Review Date: 5 Mar 2024 | Biostatus Limited
Great results!
Confocal microsopy
The product is highly effective for confocal microscopy use and easy to use. We could achieve high-quality and reproducible results. Quality meets the value of money, also considering the after-sales care.
Review Date: 15 Jan 2024 | Biostatus Limited
Great Result!
Staining Nuclei
The staining result was of high quality.
Review Date: 15 Dec 2023 | Biostatus Limited
Great nuclear counterstain
Nuclear counterstaining in fluorescence microscopy
DRAQ5 is a bright and easy-to-use nuclear counterstain in the red part of the spectrum. It doesn't require washing after incubation and hence can save you a couple of minutes in the lab.
Review Date: 13 Nov 2023 | Biostatus Limited
A bacterial DNA DRAQ5 was added to differentiate them from the background.
labeling bacterial viability for flow cytometry and confocal microcopy analysis
We ordered the product from Thermo Fisher. It is very easy to use in an effective and economical concentration range (after titration). Its use on fixed bacteria is a success. The protocol we have developed is the subject of a technical note: A flow cytometry method for safe detection of bacterial viability (DOI: 10.1002/cyto.a.24794)
Review Date: 13 Oct 2023 | Biostatus Limited
Great results
Cell cycle analysis of leukemia cells
We have obtained excellent results staining acute myeloid leukemia cells for flow cytometric analysis of the cell cycle.
Review Date: 21 Jul 2023 | Biostatus Limited
DRAQ5™ is a novel far-red fluorescent LIVE cell DNA dye that can be used in combination with other common fluors, especially GFP fusions & FITC-tags.
DRAQ5™ has many applications and is highly compatible with existing protocols across a wide range of instrumentation platforms. Biostatus is happy to provide extensive pre-sales technical support for your application.
Main application areas are HCS, flow cytometry and fluorescence microscopy.
- Rapid staining of dsDNA/nuclei of LIVE or fixed cells
- Easy to use - no lyse, no wash, no RNase needed
- Ideal for use with GFP & FITC labels - DRAQ5™ fluoresces in the far-red region
- Cost-effective analysis
FOR HCS LABS:
DRAQ5™ is the ideal nuclear counterstain for HCS.
It can reduce the screening time by 50%.
It permits simultaneous visualisation of the cytoplasm and the nucleus with one fluorophore!!!
Suitable for all HCS platforms including GE InCell 3000 and Evotec Technologies' Opera.